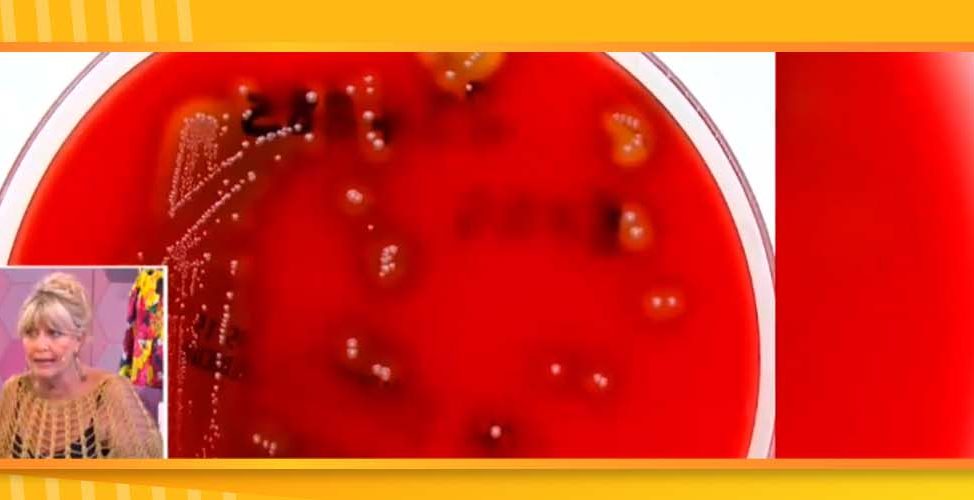

Autorizo a KUARZO ARGENTINA S.A. y/o NET TV S.A., en adelante “LAS PRODUCTORAS” y sus
respectivas casas matrices, afiliadas, subsidiarias, concesionarias, sucesores y asignatarias a hacer uso de mi
presencia para cualquier Programa televisivo (el “Programa”) y en conexión con Kuarzo Argentina S.A. y/o
NET TV S.A. u otros.
ACEPTO EXPRESAMENTE QUE:
1. Autorizo expresa, irrevocable e incondicionalmente a la transmisión, retransmisión, reproducción o
publicación de los Materiales en todos y cualquier medio de comunicación incluyendo, sin limitación
alguna.
2. Se realicen grabaciones y se tomen fotografías de mi persona, graben mi voz, conversaciones, dichos,
hechos y sonidos, durante y en conexión con mi participación en el Programa (en adelante, los
“Materiales”), sin que deban pagarme compensación alguna. Autorizo a LAS PRODUCTORAS y/o al
Canal a exhibir, reproducir o publicar en cualquier forma tales fotografías, filmaciones y/o grabaciones
en cualquier y todos los medios de comunicación, inclusive en las promociones del Programa y presto
conformidad para que se publique mi nombre. A tal efecto, otorgo mi consentimiento expreso para ser
filmado, grabado y/o fotografiado y para que las filmaciones, grabaciones e imágenes resultantes sean
exhibidas, reproducidas o publicadas por LAS PRODUCTORAS y/o el Canal.
3. Acepto que LAS PRODUCTORAS y/o el Canal serán los dueños exclusivos de los resultados y
ganancias de los Materiales con el derecho al registro de propiedad intelectual, al uso y otorgamiento
de permisos para que otros lo usen, en cualquier forma y mediante cualquier medio. En consecuencia,
autorizo expresa, irrevocable e incondicionalmente a la transmisión, retransmisión, reproducción o
publicación de los Materiales en todos y cualquier medio de comunicación incluyendo, sin limitación
alguna, los servicios de televisión por aire, antena, cable o satélite, radio, medios gráficos, cine,
Internet (incluyendo, sin limitación, “streaming”, descargas (“downloads”), “webcasting”, y video “on
demand”) y servicios móviles y/o inalámbricos (incluyendo, sin limitación, “streaming”, descargas
(“downloads”), “podcasting” y “wireless media”), en su totalidad o en una porción, con cualquier
finalidad, sin límite de tiempo y no encontrándose dicha autorización limitada a la República Argentina
y sin estar obligada LAS PRODUCTORAS y/o el Canal a realizar ningún tipo de pago adicional.
ME COMPROMETO EXPRESAMENTE A:
Guardar estricta confidencialidad acerca de toda la información que Uds. pongan en mi conocimiento que tenga
algún tipo de relación con el Programa. No compartiré dicha información con terceras personas. Me obligo a
realizar todos los actos razonablemente necesarios y adoptar todas las medidas conducentes para asegurar
que la información recibida no sea utilizada por terceros, revelada o divulgada, total o parcialmente. No utilizaré
la información para otro propósito que el de participar en el Programa. Acepto y comprendo que el
incumplimiento por mi parte de lo anteriormente descripto traerá aparejadas consecuencias sumamente graves
para Uds. y que, por lo tanto, deberé indemnizarlos por los daños y perjuicios que tal violación les ocasione.
Por la presente renuncio a mi derecho de inspección o aprobación de mi presentación o los usos de que tal
presentación se haga. Asimismo, acuerdo no presentar ningún reclamo de ninguna naturaleza en absoluto
contra nadie en relación con el ejercicio del permiso otorgado por la presente.